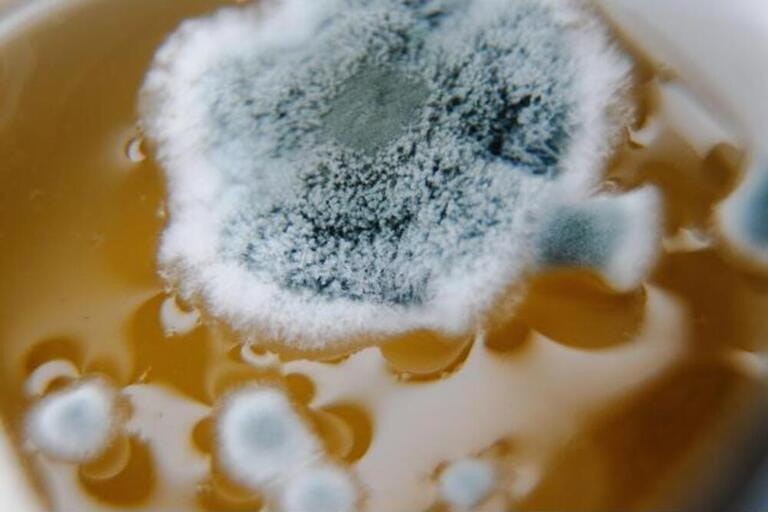

Beer is a beloved beverage for many, but like any food or drink, it can go bad under certain conditions. Here's what you need to know about beer going moldy:
What Causes Beer to Grow Mold?
There are a few key factors that can cause mold growth in beer:
Exposure to oxygen - When beer is exposed to oxygen, it creates an environment where mold can thrive. This is why you should limit oxygen exposure by storing beer in air-tight containers and drinking it soon after opening. Unpasteurized craft beers in particular need to be consumed quickly once opened.
Warm temperatures - Storing beer above room temperature gives mold spores a chance to germinate and grow. Keep beer stored cool, ideally at 55°F or lower. Higher alcohol beers have more leeway, but in general keep all beer cool.

Contamination - If mold spores manage to get into an opened beer, whether from the air, utensils, or your mouth, they can start to multiply if the beer is left out too long. This is why you shouldn't let glasses or bottles sit out overnight.
Expired beer - Old beer past its prime can start to grow mold as the alcohol content decreases and oxygen increases inside the container over time. This is why you should drink beer before the expiration or "best by" date.
What Does Moldy Beer Look Like and Smell Like?
Moldy beer will have visual signs of contamination. You may see fuzzy mold filaments or dots on the surface of the beer. The color can range from white to green to black. The beer's appearance will look hazy or spoiled underneath the mold.
There will likely be an unpleasant musty, damp smell that intensifies as the mold grows. The beer's original aroma and flavor will be compromised. The taste is often described as dirt-like, moldy, or rotten.
If you detect any off smells or noticefuzziness in your beer, do not drink it. The mold may continue to spread quickly after it's visible. When in doubt, pour it out.
Is Moldy Beer Dangerous?
Most molds are not hazardous, but it's still not worth the risk. There are a few kinds of mold such as Aspergillus that can produce mycotoxins which cause health issues when ingested. The mold Penicillium can trigger allergies or asthma symptoms.
Drinking moldy beer could lead to symptoms like diarrhea, vomiting, and stomach pain. Those with compromised immune systems are especially vulnerable.
Even if the beer doesn't make you visibly ill, mold can give beer an extremely unpleasant, musty taste. It's better not to drink any beer you suspect has mold.
How to Prevent Beer From Molding
Here are some tips for keeping your beer mold-free:
- Always refrigerate beer after opening. Keep at 40°F or below.
- Avoid exposing beer to oxygen by using bottle stoppers or caps. Limit pouring into glasses.
- Drink beer within 3-5 days of opening if it's an IPA or other hoppy style. Drink other styles within 1-2 weeks.
- Inspect beer before drinking. Look for surface mold and check the smell.
- Keep your glassware clean. Don't let glasses sit out with residue.
- Check dates and don't buy or drink expired beer.
- Store unopened beer upright and away from light if cellaring. Avoid temperature fluctuations.
- If a bottle seems under-carbonated, has floaties, smells off, or tastes bad, don't take any chances. Pour it out.
What to Do If You Find Moldy Beer

If you discover mold growth in a beer you were planning to drink:
- Don't open the container if it's still sealed. This prevents mold spores from spreading through the air.
- Discard the beer following your area's food waste protocol if it's already open. Never pour moldy beer down the drain.
- Clean the area where you found the beer with soap and water to remove any lingering spores.
- Inspect your refrigerator or cellar for other moldy beers and properly dispose of them. Clean the area thoroughly.
- If mold reappears quickly, it's a sign you need to clean more diligently or fix refrigerator issues. Maintain a temperature of 38°F or below.
- Examine your beer habits. Are you storing beer for too long after opening or exposing it to swings in temperature? Improve your beer handling practices.
While moldy beer may seem like a lost cause, being proactive about storage and hygiene will keep your brews tasting fresh. Taking quick action at the first sign of mold will help protect the rest of your beer stash.
FAQ about Moldy Beer
1. How can I tell if beer is going moldy?
Look for visible fuzziness, dots, or stringy filaments on the beer's surface that could be mold. Off smells like musty, dirt, or rotten are a giveaway too. The beer may taste stale or funky. If anything seems "off", don't drink it.
2. Can I just skim the mold off the top and still drink the beer?
No, you shouldn't take any chances. Even if you can't see tendrils elsewhere, mold roots can run deep in liquid. Skimming the surface mold doesn't remove the rest. Always toss out the full beer to avoid getting sick.
3. Does alcohol prevent beer from growing mold?
High alcohol beers have more mold resistance, but they can still grow mold once opened and exposed to air. No beer, even heavy stouts or barleywines, is immune after opening. Refrigerate and consume them within a week or two.
4. Is draft beer at bars ever at risk for mold?
If draft lines and taps are properly cleaned, draft beer shouldn't grow mold. A dirty tap system however can lead to contamination. Check your glass for any fuzziness or film on the beer's surface before drinking as an extra precaution.
5. Can I return moldy beer to the store?
Most retailers will not accept returns on food products. However, if multiple bottles from the same batch or brewery seem moldy, it's worth alerting the beer manager to a potential quality issue. You can usually exchange one moldy beer for a replacement.
Conclusion
While beer is designed to resist fermentation from stray yeast and bacteria, mold spores in the air and poor storage conditions can still cause spoilage issues. Always keep beer cool, limit oxygen exposure, and drink opened bottles quickly. Check for any fuzziness, haze, or sour odors before consuming. Promptly discard any suspect beers and clean equipment to stop mold in its tracks. With proper handling, you can keep sipping your favorite brews mold-free.